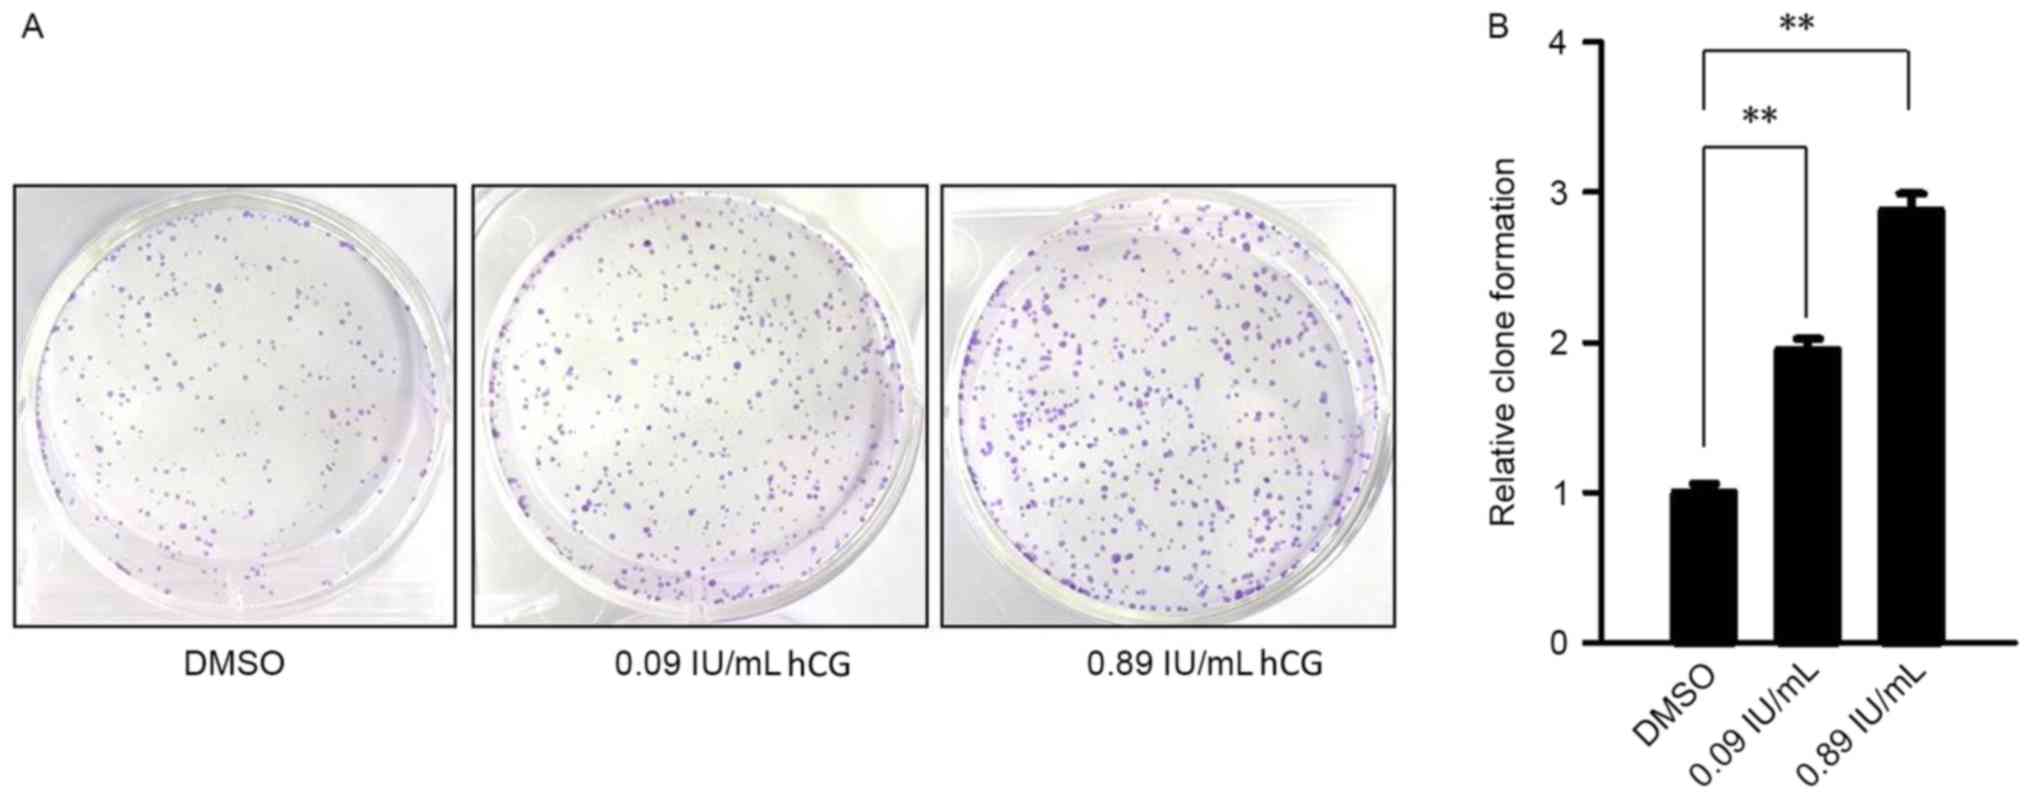

Introduction
In its physiological state, human chorionic
gonadotropin (hCG) is a type of growth factor, and an essential
signaling molecule in the process of embryonic development, which
stimulates the proliferation and differentiation of ovarian
epidermal cells and controls the growth of follicle and corpus
luteum formation (1). Additionally,
one previous study (2) revealed that
hCG is able to promote the expression of other growth factors,
including estrogen in ovarian tissue and hepatocyte growth factor
(HGF), and regulates cell division, morphology and cell apoptosis
(3,4).
hCG is associated with numerous tumor-associated genes; for
example, hCG regulates tumor suppressor genes and oncogenes in a
dose-dependent manner including tumor protein p53, cyclin-dependent
kinase inhibitor p21WAF1/Cip1, c-Fos, c-Jun and c-Myc
(5–10). hCG is likely to affect cell
proliferation and differentiation through growth factors or cancer
genes, including that it induces the expression of cancer genes
c-Myc, c-Jun and inhibin, in addition to affecting the
differentiation of udder cells (11).
hCG is also able to stimulate the growth of Kaposi's sarcoma cell
(12).
Gastric cancer is a type of complex tumor that
involves polygenes, multiple stages and migration (13,14).
Hormones, oncogenes, tumor suppressor genes and growth factors are
involved in the process in different ways to varying degrees and at
different stages (15). Although
there is a lot of evidence demonstrating that hCG has a strong
association with the differentiation and metastasis of gastric
cancer cells (16,17), its mechanism in gastric cancer remains
unclear. Therefore, an in-depth study of the biological effect of
hCG in gastric cancer will broaden current understanding of the
development process of gastric cancer and help to develop earlier
and more effective methods of endocrine therapy.
Through number of gastric cancer-associated genes,
the overexpression of HGF transmembrane protein receptor (c-Met)
gene exerts effects throughout the whole process of occurrence,
development and outcome of gastric cancer. c-Met is a
proto-oncogene coding receptor with tyrosine kinase activity
(18). Additionally, c-Met is highly
expressed in epithelial cells (19).
HGF mainly regulates cell migration through c-Met in normal cells,
however, in the process of cellular oncogenesis, it serves a
critical role in tumor growth and evolution (18). Studies have revealed that c-Met is
associated with the occurrence, metastasis and prognosis of gastric
cancer (18,20,21). At
present, it is generally believed that it is the presence of c-Met
in the process of gastric cancer formation that results in gastric
cancer differentiating into two cell types: The intestinal and the
diffuse types (21).
In order to investigate the function of hCG in
gastric cancer, the expression of hCG and its receptor were
detected in gastric cancer tissue, and by stimulating the gastric
cancer cell line SGC-7901 with hCG, the effect of hCG on the
proliferation of gastric cancer cells was examined Furthermore by
measuring the expression of the gastric cancer associated gene
c-Met, the present study aimed to reveal the molecular mechanism of
hCG in gastric cancer.
Materials and methods
Patients
The paraffin-embedded tissue samples of gastric
cancer and para-carcinoma tissue from 62 patients (30 males and 32
females), aged from 38 to 82 years old (median age, 60 years old),
were collected from Sichuan Cancer Hospital (Chengdu, China)
diagnosed with gastric carcinoma between January 2010 to December
2012 at Sichuan Cancer Hospital, which were prepared for
immunohistochemical detection. The staging of cancer was determined
according to the tumor-node-metastasis (TNM) classification, using
the American Joint Committee on Cancer (AJCC) recommendations
(22). The present study was approved
by the Institutional Review Board of the Sichuan Cancer Hospital
and written informed consent was obtained from all patients prior
to the study.
Immunohistochemical staining
Gastric cancer tissues were collected during surgery
and fixed in 10% formalin for 24 h at 18°C, prior to paraffin
embedding. Paraffin sections (4-µm thick) of gastric cancer tissues
were mounted on silanized slides, dewaxed at 65°C for 1 h,
deparaffinized with xylene at room temperature for 5 min and
rehydrated using ethanol (100, 100, 95, 85, 75 and 75% ethanol, 3
min at room temperature). Following washing with PBS for 3 min at
room temperature, endogenous enzymes were removed using 0.3%
hydrogen peroxide/methanol solution at 37°C for 15 min, followed by
washing with PBS and drying. A total of 10% bovine serum albumin
(BSA; Merck KGaA, Darmstadt, Germany) was added to block
nonspecific binding sites at 37°C for 15 min. Primary antibodies
against (dilution, 1:50; cat no. C8534; Sigma-Aldrich, Merck KGaA,
Darmstadt, Germany,) or hCG receptor (hCGR; dilution, 1:400; cat
no. ab204950; Abcam, Cambridge, UK) were applied overnight at 4°C.
Following washing three times in PBS for 3 min at room temperature,
immunodetection was performed using a labeled polymer horseradish
peroxidase mouse antibody (cat no. SC-51948; dilution, 1:100; Santa
Cruz Biotechnology, Inc., Dallas, TX, USA) incubated for 10 min at
room temperature. Slides were subsequently washed with PBS for 3
min at room temperature, visualized with 3,3′-diaminobenzidine for
10 min and counterstained with Mayer's hematoxylin for 10 min at
room temperature. The expression intensity of the target proteins
in the tissues was determined by the positive cell number and
staining intensity. The expression of hCG and its receptor in
gastric cancer tissue and para-carcinoma tissue was then
compared.
Cell culture and treatment
Gastric cancer cell line SGC-7901 was acquired from
Shanghai Cell Bank (Shanghai, China) and was maintained in
RPMI-1640 medium (Pierce; Thermo Fisher Scientific, Inc., Waltham,
MA, USA) containing 10% fetal bovine serum (FBS; Gibco; Thermo
Fisher Scientific, Inc.) at 37°C and 5% CO2 in a
saturated humidity cultivation box. To study the effect of hCG on
cancer cell proliferation, SGC-7901 cells were treated at 37°C for
5 days with hCG at the logarithmic phase using 0.09 and 0.89 IU/ml
hCG, and the cells were divided into three groups: A control group
(treated with PBS), a 0.09 IU/ml hCG-treated group and a 0.89 IU/ml
hCG-treated group. To study the effects of blocking the protein
kinase A (PKA) signaling pathway on the function of hCG, cAMP
dependent protein kinase peptide inhibitor (PKAI) (Promega
Corporation, Madison, WI, USA) was used for the specific binding of
PKA 5–24 amino acids. A total of 10 µmol/l PKAI was added to serum
free cultured SGC-7901 cells treated with 0 and 0.09 IU/ml hCG, and
hCG-only treatment was used as the control.
Cell proliferation curve using cell
counting kit-8 (CCK-8)
SGC-7901 cells at a density of 2×103 per
well in 96-well plates were cultured for 5 days with hCG at
concentrations of 0, 0.09 and 0.89 IU/ml, and equal amounts of PBS
were added to the control group. Experiments were performed in
triplicate in serum-free RPMI-1640 medium at 37°C and 5%
CO2. CCK-8 (Dojindo Molecular Technologies, Inc.,
Kumamoto, Japan) was added to make up a final concentration of 10%
and incubated with the cells at 37°C for 2 h. Absorbance was
measured at 450 nm using a plate reader (American Stat Fax-2100).
An average of three repeats were performed to obtain the SGC-7901
cell proliferation curve of cells treated with hCG at days 1, 2, 3,
4 and 5 post-treatment.
Cell cycle analysis by flow
cytometry
Cells at a density of 2.5×105 cells/well
were distributed into 6-well plates and subjected to incubation for
48 h. RPMI-1640 medium supplemented with 10% FBS was used for cell
culture and incubation was performed at 37°C in an atmosphere of 5%
CO2. The medium was then replaced with fresh RPMI-1640
medium containing fisetin (15 µM) in DMSO. Following 48 h
incubation at 37°C, the cells were subjected to trypsinization and
subsequent washing with cold PBS. The cells were then fixed with
70% ethyl alcohol at 4°C for at least 4 h, followed by addition of
20 µl RNase (Thermo Fisher Scientific,) and 20 µl PI
(Sigma-Aldrich; Merck KGaA). The cells were then incubated for 30
min at 37°C prior to analysis using a FACSCalibur flow cytometer
(BD Biosciences) and CellQuest software version 3.3 (BD
Biosciences).
Cells treated with 0.09 and 0.89 IU/ml hCG were
collected at a density of 1×106 per test tube and
centrifuged at 250 × g at 4°C for 5 min. The supernatant was then
discarded and 1 ml 70% ethanol was added at 20°C to the test tubes,
mixed using oscillation, and stored at −20°C. The cell samples were
then centrifuged at 250 × g at 4°C for 5 min to remove the
supernatant for DNA staining. Next, 1 ml DNA staining solution
containing 20 µl RNase (Thermo Fisher Scientific, Inc.) and 20 µl
PI (Sigma-Aldrich; Merck KGaA) was added. The cells were then
incubated for 30 min at 37°C prior to analysis using a FACSCalibur
flow cytometer (BD Biosciences) and CellQuest software version 3.3
(BD Biosciences). All experiments were repeated three times.
Colony formation assay
SGC-7901 cells were cultivated in 6-well plates at a
density of 4×102 per well with RPMI-1640 medium at 37°C
and 5% CO2. The cells were separated into three groups
treated at 37°C for 7 days with hCG at concentrations of 0, 0.09
and 0.89 IU/ml. Each group had three repeated experiments for 2
continuous weeks of culture; the cells were then washed twice with
PBS, fixed for 30 min at room temperature with paraformaldehyde,
then stained using 10 mg/ml Giemsa for 20 min at room temperature.
The number of cell clones was counted by light microscopy
(magnification, ×100) and the colony formation rate was calculated
as follows: Colony formation rate=(colony count/Inoculation cell
number) ×100%. All experiments were performed three times.
Western blot analysis
SGC-7901 cells were lysed using RIPA buffer (Pierce;
Thermo Fisher Scientific, Inc.) and the total protein was
extracted. Protein concentration was determined using a Bio-Rad
protein assay system (Bio-Rad Laboratories, Inc., Hercules, CA,
USA), according to the manufacturer's protocol. A total of 50 g
protein was separated by 10% SDS-PAGE, transferred into
polyvinylidene difluoride membranes (GE Healthcare, Chicago, IL,
USA), and blocked at room temperature for 30 min in 10 mM
Tris-buffered saline containing 0.1% (v/v) Tween.20 (TBST) and 5%
(w/v) skimmed milk. The membranes were incubated overnight at 4°C
with the following primary antibodies at a dilution of 1:1,000. The
primary antibodies used in the experiments were: Rabbit GAPDH (cat.
no. 2118; Cell Signaling Technology, Inc., Danvers, MA, USA) and
c-Met (cat. no. 8198; Cell Signaling Technology, Inc.). Subsequent
to washing with TBST, the membranes were incubated with horseradish
peroxidase-conjugated sheep anti-rabbit immunoglobulin G (cat. no.
04-15-06 KPL, Inc., Gaithersburg, MD, USA) as a secondary antibody
at a dilution of 1:2,000 for 1 h at 37°C. The membranes were then
washed with TBST three times. Membranes were drained of TBST and
exposed to the enhanced chemiluminescence (ECL) reagent substrate
(Thermo Fisher Scientific, Inc.). Following being allowed to stand
undisturbed for 90 sec, the membrane was drained of ECL detection
reagent. The membrane was wrapped and exposed to X-ray film
(Fujifilm, Shanghai, China).
Animal studies
A total of 20 4-week-old male BALB/c nude mice (15
g) were purchased from Vital River Laboratory Animal Technology Co.
Ltd., (Beijing, China). Mice were housed in a temperature at 27°C,
50% relative humidity, alternately exposed to light for 10 h and
without light for 14 h pathogen-free environment. All mice had free
access to food and water. Subcutaneous tumors were generated by
subcutaneous injection of 2×106 SGC-7901 cells under the
right forelimb of each mouse. Tumor growth was observed daily in
each group and tumor diameter was measured once a week using
calipers. After 7 days, the mice were randomly assigned into 2
groups (10 mice in each group) and treated with or without hCG (890
IU/kg/day) via intraperitoneal injection for 20 consecutive days.
The mice in the control group were administrated the 1 ml/kg/day
dimethylsulfoxide. Tumor size was measured and the volume was
calculated according to the following formula: Tumor volume
(mm3)=d2 × D/2, where d and D were the shortest and
longest diameter, respectively. At 4 weeks post-injection, the mice
were sacrificed, or when the maximum tumor diameter reached 2.0 cm.
The tumors were excised and weighed. All animal experiments were
approved by the Institution of Animal Care and Use Committee of
Sichuan Cancer Hospital.
Statistical analysis
All experiments were repeated three times, and
quantitative data were presented as the mean ± standard deviation.
Associations between protein expression and clinicopathological
parameters of the patients were assessed using χ2 test.
The comparison of mean values between two groups used an unpaired
Student's t-test; and data analysis between three groups was
performed using one-way analysis of variance with a least
significant difference test for post hoc analysis. P<0.05 was
considered to indicate a statistically significant difference. All
statistical analysis was performed using SPSS13.0 statistical
software package (SPSS, Inc., Chicago, IL, USA).
Results
hCG and hCGR are highly expressed in
gastric cancer tissues
The result of immunohistochemical analysis revealed
that hCG and hCGR were highly expressed in gastric cancer samples,
and were notably higher compared with that of para-carcinoma
tissues (Fig. 1). Furthermore, the
expression of hCG and hCGR in poorly differentiated gastric cancer
was significantly higher compared with that in well/moderately
differentiated gastric cancer (P<0.01), particularly in
well/moderately differentiated gastric cancer tissue (Table I).
 | Table I.hCG and hCGR expression in gastric
cancer tissues. |
Table I.
hCG and hCGR expression in gastric
cancer tissues.
|
|
| hCG | hCGR |
|---|
|
|
|
|
|
|---|
| Parameters | n | Low | High | P-value | Low | High | P-value |
|---|
| All tissues | 62 | 37 | 25 |
| 35 | 27 |
|
| Age, years |
|
|
| 0.437 |
|
| 0.796 |
|
<60 | 31 | 20 | 11 |
| 17 | 14 |
|
|
≥60 | 31 | 17 | 14 |
| 18 | 13 |
|
| Sex |
|
|
| 0.960 |
|
| 0.960 |
|
Male | 30 | 18 | 12 |
| 16 | 14 |
|
|
Female | 32 | 19 | 13 |
| 19 | 13 |
|
| Differentiation
grade |
|
|
| <0.001 |
|
| <0.001 |
|
Well/moderate | 40 | 31 | 9 |
| 28 | 12 |
|
|
Poor | 22 | 6 | 16 |
| 7 | 15 |
|
| pT |
|
|
| 0.272 |
|
| 0.960 |
|
T1-T2 | 25 | 15 | 10 |
| 16 | 13 |
|
|
T3-T4 | 37 | 20 | 17 |
| 19 | 14 |
|
hCG promotes SGC-7901 cell
proliferation
Given that the expression of hCG and hCGR was
identified to be highly expressed in poorly differentiated gastric
cancer, which is characterized by its high proliferation ability,
it was hypothesized that hCG may be involved in the regulation of
cell proliferation of gastric cancer. CCK-8 analysis revealed that
SGC-7901 cells in the control and hCG-treated groups began to
proliferate on day 2 and entered the logarithmic phase on day 3
with a good-state proliferation curve. Cells treated with 0.09
IU/ml hCG had significantly higher proliferation rate compared with
the control group (P<0.01), and cells treated with 0.89 IU/ml
hCG had a significantly higher cell proliferative ability compared
with that of control cells (P<0.001). All the above indicated
that hCG had an effect on the proliferative ability of SGC-7901
cells with concentration ranging from 0.09 to 0.89 IU/ml in a
dose-dependent manner (Fig. 2).
hCG induces cell cycle G2/M-phase
arrest in SGC-7901 cells
Flow cytometry revealed that hCG is able to promote
the number of G2/M phase cells a compared with control
cells (Fig. 3 and Table II).
 | Table II.Dose-dependent effect of hCG on the
cell cycle of SGC-7901 cells. |
Table II.
Dose-dependent effect of hCG on the
cell cycle of SGC-7901 cells.
|
| hCG, IU/ml |
|---|
|
|
|
|---|
| Cell cycle
phase | 0 | 0.09 | 0.89 |
|---|
|
G0/G1 | 85.1 | 76.6 | 68.2 |
| S |
3.6 |
3.3 |
8.0 |
|
G2/M | 11.2 | 20.0 | 23.7 |
hCG promotes colony formation
abilities of SGC-7901 cells
Results of a colony formation assay revealed that
with the increase of hCG concentration, there was a significantly
increased number of colonies formed on the plates compared with the
control group. hCG treatment at a concentration of 0.09 IU/ml
significantly increased the colony formation rate by ~1.95±0.12
(P<0.01) and hCG at 0.89 IU/ml significantly increased the clone
formation rate by ~2.88±0.20 compared with the control group
(P<0.01; Fig. 4).
hCG promotes the expression of c-Met
in SGC-7901 cells
With the increase of hCG concentration, hCG promoted
the protein expression of c-Met in a dose-dependent manner in
SGC-7901 cells (Fig. 5A). Further
experiments which used an inhibitor PKAI to block the PKA signaling
pathway demonstrated that once the PKA signaling pathway was
blocked, it inhibited the increased activation of c-Met expression
that resulted from hCG treatment (Fig.
5B). The above results revealed that hCG is able to promote the
expression of c-Met in SGC-7901 cells, which relies on the PKA
signaling pathway.
hCG promotes tumor growth in vivo
The role of hCG in promoting cell proliferation, as
presented in Fig. 2, indicate that
hCG may function as an activator in carcinogenesis. To determine
the contribution of hCG to cancer pathogenesis, well-established
in vivo grafting models of experimental gastric cancer were
established, which were randomly assigned into 2 groups and treated
with or without hCG (890 IU/kg/day) via intraperitoneal injection
for 20 consecutive days. At the end of the study, the nude mouse
transplantation tumor experiment revealed that the tumors of the
mice in the hCG-treated group were significantly larger compared
with that of the control group (P<0.001; Fig. 6). This result indicates that hCG
serves a key role in promoting tumor growth.
Discussion
At present, accumulated evidence demonstrates that
hCG is associated with the cell differentiation and the metastasis
of gastric cancer (23,24), however, its mechanism in gastric
cancer development remains largely unknown. Further study of the
biological effect of hCG in gastric cancer will broaden current
understanding of the development process of gastric cancer and
allow for earlier and more effective endocrine therapy. In the
present study, it was demonstrated that hCG and its receptor had
abnormally high expression in gastric cancer tissues, and that hCG
promoted cell proliferation by activating the expression of c-Met,
which relied on the PKA signaling pathway.
The affinity and capacity of hCGR expressed in
gastric cancer tissue are higher compared with that in normal
gastric mucosa with radioactive ligand labeling (25). In the present study, it was also
confirmed that the positive rate of hCG and hCGR expressed in
gastric cancer tissue was higher compared with that of
para-carcinoma tissues, suggesting that hCG and hCGR were potential
diagnostic markers of gastric cancer.
Through further experimental analysis, it was
demonstrated that hCG at the low concentration of 0.09 IU/ml was
able to serve a role in promoting cell proliferation as an
oncogene. hCG promotes lymphocyte proliferation in a dose-dependent
manner in physiological conditions (26). hCG at 0.1 IU/ml is able to promote the
cell proliferation of Leydig cells and granulosa cells (9,27), and hCG
stimulates myometrium cell growth at a concentration of 3 nmol/l
(28). The concentration of hCG in
serum at the early stages of pregnancy is as high as 160 IU/ml, and
is maintained at ~10 IU/ml in serum in the middle-late stages,
finally disappearing rapidly postpartum (29). If no hCG residue is present in the
placenta, the hCG serum concentration falls to 1 IU/ml 4 days
postpartum, and cannot be detected after 9 days (30). Based on these results, hCG
concentration should be <1 IU/ml under normal physiological
conditions.
The effect of hCG on cell growth is achieved through
luteinizing hormone/hCGR (31).
Ala-Fossi et al (32) revealed
that the effect of hCG on cell growth depends on its receptor, and
in ovarian epithelial carcinoma cell lines without hCGR expression,
it neither promotes cell growth nor alters the expression of
growth-associated factors. In the present study, it was also
revealed that the high ectopic expression of hCG in gastric cancer
tissue was accompanied by the high expression of hCGR, suggesting
that hCG served the role of proto-oncogene, which relied on its
receptor signal transduction.
Growth factors in serum may potentially stimulate
the expression of genes in cells; for example, epidermal growth
factor is able to upregulate multiple genes including c-Fos, c-Jun
and c-Myc (33–35), serum-free culture was used to
establish cells in their resting state, maintaining gene and
cytokine levels in the cells at a physiological level. When exposed
to exogenous stimuli, the effect of cell growth may be started or
inhibited. The number of cells at the S and G2/M phase
were increased, with a corresponding loss of cells at the
G0/G1 phase, an increased PI value and
increased DNA synthesis, cell division and decreased static cells.
Kim et al (36) treated
granulosa cells with hCG for 3 days, and the number of cells at the
S and G2/M phase were significantly higher compared with
untreated cells.
Numerous experiments in vitro and in
vivo have revealed that hCG effects the expression of oncogenes
including c-Fos (37), c-Jun
(38) and c-Myc (39) in a time- and dose-dependent manner.
The experimental results of the present study were in conformity
with these previous studies, and the activation of c-Met by hCG in
gastric cancer cells should be considered a physiological
phenomenon. The PKA signaling pathway mainly promotes cell
proliferation (5). In the present
study, it was also demonstrated that the ability of hCG to promote
cell proliferation depended on the PKA signaling pathway. These
results suggested that hCG may be one of the initial factors for
the expression of c-Fos, c-Jun and c-Myc in gastric cancer.
Therefore, hCG promotes the process of gastric cancer and tumor
metastasis through inducing the expression of c-Met.
In conclusion, the present study confirmed that hCG
and its receptor had high expression in gastric cancer tissue, and
hCG activated the expression of c-Met through its receptor and the
PKA signaling pathway to promote gastric cancer cell proliferation.
The present study further revealed the potential function of hCG in
the development of gastric cancer, suggesting that hCG may be a
molecular marker in the early diagnosis of gastric cancer, in
addition to being a potential drug target for treatment of gastric
cancer.
Acknowledgements
The authors would like to thank the Experimental
Animal Center of West China Center of Medical Sciences (Chengdu,
China) for animal feeding.
Funding
The present study was supported by grants from the
National Natural Science Foundation of China (grant no. 81502075),
the Foundation of Science and Technology of Sichuan Province (grant
nos. 2014JY0136, 2014JY0017 and 2015FZ0072), the Foundation of
Science and Technology of Chengdu City (grant nos.
2015-HM01-00141-SF, 2015-HM01-00143-SF and 2015-HM01-00139-SF).
Availability of data and materials
All data generated or analyzed during the present
study are included in this published article.
Authors' contributions
RZ and TZ collected clinical tissues. WX, XS, LZ and
YG performed the in vitro experiments. CZ and YB designed
the study and revised the manuscript.
Ethics approval and consent to
participate
The present study was approved by the Ethics
Committee of Sichuan Cancer Hospital (Chengdu, China). Written
informed consent was obtained from all patients.
Patient consent for publication
Written informed consents for the publication of
this data were obtained from all patients in the present study.
Competing interests
The authors declare that they have no competing
interests.
References
|
1
|
Richards JS, Fitzpatrick SL, Clemens JW,
Morris JK, Alliston T and Sirois J: Ovarian cell differentiation: A
cascade of multiple hormones, cellular signals, and regulated
genes. Recent Prog Horm Res. 50:223–254. 1995.PubMed/NCBI
|
|
2
|
Parrott JA, Doraiswamy V, Kim G, Mosher R
and Skinner MK: Expression and actions of both the follicle
stimulating hormone receptor and the luteinizing hormone receptor
in normal ovarian surface epithelium and ovarian cancer. Mol Cell
Endocrinol. 172:213–222. 2001. View Article : Google Scholar : PubMed/NCBI
|
|
3
|
Yang Y, Adachi K, Sheridan MA, Alexenko
AP, Schust DJ, Schulz LC, Ezashi T and Roberts RM: Heightened
potency of human pluripotent stem cell lines created by transient
BMP4 exposure. Proc Natl Acad Sci USA. 112:E2337–E2346. 2015.
View Article : Google Scholar : PubMed/NCBI
|
|
4
|
Cole LA and Butler S: Hyperglycosylated
hCG, hCGβ and Hyperglycosylated hCGβ: Interchangeable cancer
promoters. Mol Cell Endocrinol. 349:232–238. 2012. View Article : Google Scholar : PubMed/NCBI
|
|
5
|
Yaron Y, Schwartz D, Evans MI, Aloni R,
Kapon A and Rotter V: p53 tumor suppressor gene expression in the
mouse ovary during an artificially induced ovulatory cycle. J
Reprod Med. 44:107–114. 1999.PubMed/NCBI
|
|
6
|
Hastings JM, Jackson KS, Mavrogianis PA
and Fazleabas AT: The estrogen early response gene FOS is altered
in a baboon model of endometriosis. Biol Reprod. 75:176–182. 2006.
View Article : Google Scholar : PubMed/NCBI
|
|
7
|
Yuri T, Kinoshita Y, Emoto Y, Yoshizawa K
and Tsubura A: Human chorionic gonadotropin suppresses human breast
cancer cell growth directly via p53-mediated mitochondrial
apoptotic pathway and indirectly via ovarian steroid secretion.
Anticancer Res. 34:1347–1354. 2014.PubMed/NCBI
|
|
8
|
Devi GR, Oldenkamp JR, London CA and
Iversen PL: Inhibition of human chorionic gonadotropin beta-subunit
modulates the mitogenic effect of c-myc in human prostate cancer
cells. Prostate. 53:200–210. 2002. View Article : Google Scholar : PubMed/NCBI
|
|
9
|
Garcia Mori Sequeiros M, Gomez NV,
Gorostizaga A, Acquier A, Gonzalez-Calvar SI, Mendez CF and Paz C:
MAP kinase phosphatase-3 (MKP-3) is transcriptionally and
post-translationally up-regulated by hCG and modulates cAMP-induced
p21 expression in MA-10 Leydig cells. Mol Cell Endocrinol.
371:174–181. 2013. View Article : Google Scholar : PubMed/NCBI
|
|
10
|
Maheshwari A, Misro MM, Aggarwal A and
Sharma RK: N-acetyl-L-cysteine modulates multiple signaling
pathways to rescue male germ cells from apoptosis induced by
chronic hCG administration to rats. Apoptosis. 17:551–565. 2012.
View Article : Google Scholar : PubMed/NCBI
|
|
11
|
Jiang X, Russo IH and Russo J: Human
chorionic gonadotropin and inhibin induce histone acetylation in
human breast epithelial cells. Int J Oncol. 20:77–79.
2002.PubMed/NCBI
|
|
12
|
Dricu A, Sergiu-Bogdan C, Brismar K,
Biberfeld P and Andersson LC: A synthetic peptide derived from the
human eosinophil-derived neurotoxin induces apoptosis in Kaposi's
sarcoma cells. Anticancer Res. 24:1427–1432. 2004.PubMed/NCBI
|
|
13
|
De Vita F, Di Martino N, Fabozzi A,
Laterza MM, Ventriglia J, Savastano B, Petrillo A, Gambardella V,
Sforza V, Marano L, et al: Clinical management of advanced gastric
cancer: The role of new molecular drugs. World J Gastroenterol.
20:14537–14558. 2014. View Article : Google Scholar : PubMed/NCBI
|
|
14
|
Liang L, Fang JY and Xu J: Gastric cancer
and gene copy number variation: Emerging cancer drivers for
targeted therapy. Oncogene. 35:1475–1482. 2016. View Article : Google Scholar : PubMed/NCBI
|
|
15
|
Kidd M, Gustafsson B and Modlin IM:
Gastric carcinoids (neuroendocrine neoplasms). Gastroenterol Clin
North Am. 42:381–397. 2013. View Article : Google Scholar : PubMed/NCBI
|
|
16
|
Arai O, Kakutani A, Mouri H, Ikeda H,
Notohara K and Matsueda K: A case of advanced gastric cancer
growing extramurally with gynecomastia and high hCG-beta serum
level. Gan To Kagaku Ryoho. 37:1369–1372. 2010.(In Japanese).
PubMed/NCBI
|
|
17
|
Ohi S, Takahashi N, Hashimoto H, Tachibana
T, Hirabayashi T, Sugiyama K, Yanaga K and Ishikawa H:
Establishment and characterization of an IGSK-2 cell line derived
from ascitic fluid of recurrent hCG and somatostatin secreted
adenocarcinoma of the stomach. Hum Cell. 20:52–61. 2007. View Article : Google Scholar : PubMed/NCBI
|
|
18
|
Gholamin S, Fiuji H, Maftouh M, Mirhafez
R, Shandiz FH and Avan A: Targeting c-MET/HGF signaling pathway in
upper gastrointestinal cancers: Rationale and progress. Curr Drug
Targets. 15:1302–1311. 2014. View Article : Google Scholar : PubMed/NCBI
|
|
19
|
Boccaccio C and Comoglio PM: The MET
oncogene in glioblastoma stem cells: Implications as a diagnostic
marker and a therapeutic target. Cancer Res. 73:3193–3199. 2013.
View Article : Google Scholar : PubMed/NCBI
|
|
20
|
Noguchi E, Saito N, Kobayashi M and
Kameoka S: Clinical significance of hepatocyte growth factor/c-Met
expression in the assessment of gastric cancer progression. Mol Med
Rep. 11:3423–3431. 2015.PubMed/NCBI
|
|
21
|
Marano L, Chiari R, Fabozzi A, De Vita F,
Boccardi V, Roviello G, Petrioli R, Marrelli D, Roviello F and
Patriti A: c-Met targeting in advanced gastric cancer: An open
challenge. Cancer Lett. 365:30–36. 2015. View Article : Google Scholar : PubMed/NCBI
|
|
22
|
Edge SB and Compton CC: The american joint
committee on cancer: The 7th edition of the AJCC cancer staging
manual and the future of TNM. Ann Surg Oncol. 17:1471–1474. 2010.
View Article : Google Scholar : PubMed/NCBI
|
|
23
|
Zhang W, Yang H and Han S: The effect of
ectopic HCG on microvessel density in gastric carcinoma. Zhonghua
Zhong Liu Za Zhi. 20:351–353. 1998.(In Chinese). PubMed/NCBI
|
|
24
|
Ohdaira H, Murai R, Hanyu N, Abe M and
Yanaga K: Gastric cancer producing AFP/HCG which had a rapidly
progressive course with metastasis to the brain discovered
postoperatively. Nihon Shokakibyo Gakkai Zasshi. 104:666–670.
2007.PubMed/NCBI
|
|
25
|
Rindi G, Luinetti O, Cornaggia M, Capella
C and Solcia E: Three subtypes of gastric argyrophil carcinoid and
the gastric neuroendocrine carcinoma: A clinicopathologic study.
Gastroenterology. 104:994–1006. 1993. View Article : Google Scholar : PubMed/NCBI
|
|
26
|
Bansal AS, Bora SA, Saso S, Smith JR,
Johnson MR and Thum MY: Mechanism of human chorionic
gonadotrophin-mediated immunomodulation in pregnancy. Expert Rev
Clin Immunol. 8:747–753. 2012. View Article : Google Scholar : PubMed/NCBI
|
|
27
|
Goto M, Iwase A, Harata T, Takigawa S,
Suzuki K, Manabe S and Kikkawa F: IGF1-induced AKT phosphorylation
and cell proliferation are suppressed with the increase in PTEN
during luteinization in human granulosa cells. Reproduction.
137:835–842. 2009. View Article : Google Scholar : PubMed/NCBI
|
|
28
|
Horiuchi A, Nikaido T, Yoshizawa T, Itoh
K, Kobayashi Y, Toki T, Konishi I and Fujii S: HCG promotes
proliferation of uterine leiomyomal cells more strongly than that
of myometrial smooth muscle cells in vitro. Mol Hum Reprod.
6:523–528. 2000. View Article : Google Scholar : PubMed/NCBI
|
|
29
|
Ayiasi RM, Muhumuza C, Bukenya J and Orach
CG: The effect of prenatal counselling on postpartum family
planning use among early postpartum women in masindi and
kiryandongo districts, uganda. Pan Afr Med J. 21:1382015.
View Article : Google Scholar : PubMed/NCBI
|
|
30
|
Fantz CR, Dagogo-Jack S, Ladenson JH and
Gronowski AM: Thyroid function during pregnancy. Clin Chem.
45:2250–2258. 1999.PubMed/NCBI
|
|
31
|
Ziecik AJ, Kaczmarek MM, Blitek A,
Kowalczyk AE, Li X and Rahman NA: Novel biological and possible
applicable roles of LH/hCG receptor. Mol Cell Endocrinol.
269:51–60. 2007. View Article : Google Scholar : PubMed/NCBI
|
|
32
|
Ala-Fossi SL, Grenman S, Zhang FP, Blauer
M, Punnonen R and Maenpaa J: Ovarian cancer and gonadotropins in
vitro: New evidence in favor of independence. Anticancer Res.
19:4289–4295. 1999.PubMed/NCBI
|
|
33
|
Willmarth NE and Ethier SP: Amphiregulin
as a novel target for breast cancer therapy. J Mammary Gland Biol
Neoplasia. 13:171–179. 2008. View Article : Google Scholar : PubMed/NCBI
|
|
34
|
Lin JK: Molecular targets of curcumin. Adv
Exp Med Biol. 595:227–243. 2007. View Article : Google Scholar : PubMed/NCBI
|
|
35
|
Puzianowska-Kuznicka M, Pietrzak M,
Turowska O and Nauman A: Thyroid hormones and their receptors in
the regulation of cell proliferation. Acta Biochim Pol. 53:641–650.
2006.PubMed/NCBI
|
|
36
|
Kim JM, Yoon YD and Tsang BK: Involvement
of the fas/fas ligand system in p53-mediated granulosa cell
apoptosis during follicular development and atresia. Endocrinology.
140:2307–2317. 1999. View Article : Google Scholar : PubMed/NCBI
|
|
37
|
Dos Santos E, Dieudonne MN, Leneveu MC,
Pecquery R, Serazin V and Giudicelli Y: In vitro effects of
chorionic gonadotropin hormone on human adipose development. J
Endocrinol. 194:313–325. 2007. View Article : Google Scholar : PubMed/NCBI
|
|
38
|
Yuan S, Xu S, Yang X, Liu X, Hao J and
Qian M: Effects of c-jun on hCG-induced testosterone secretion of
rat Leydig cells in vitro. Zhonghua Nan Ke Xue. 10(345–347):
3502004.(In Chinese).
|
|
39
|
Russo IH and Russo J: Hormonal approach to
breast cancer prevention. J Cell Biochem Suppl. 34:1–6. 2000.
View Article : Google Scholar : PubMed/NCBI
|